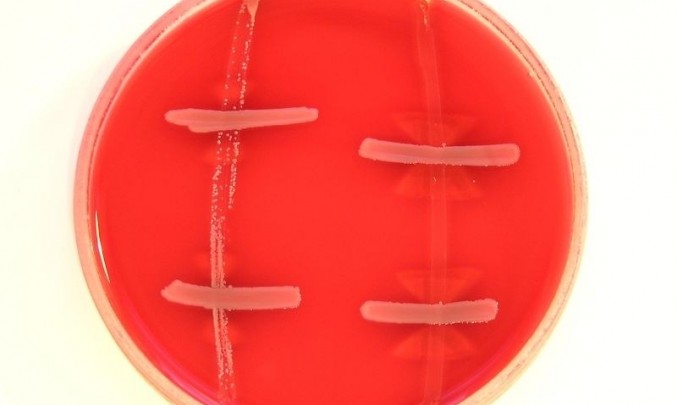

Kampylobakterové nákazy
Kampylobakterové nákazy jsou jedny z nejčastějších bakteriálních průjmových onemocnění postihujících zejména děti.
Jak se můžete nakazit?
Bakterie Campylobacter jejuni většinou žije ve střevech domácích zvířat a ptáků a jejich produkty (zvláště maso – i zmražené) jsou nejčastější cestou nákazy. Počet kampylobakterových průjmů v ČR každoročně rychle stoupá: za prvních 9 měsíců roku 2001 bylo hlášeno přes 15 000 onemocnění.
#IMG#Jak se tyto nákazy projevují?
Inkubační doba (to znamená doba od nákazy po objevení se prvních příznaků nemoci) je 2-7 dní. Onemocnění začne horečkou, únavou, bolestmi ve svalech, pak dojde k průjmům. Stolice je vodnatá, někdy s příměsí krve a nemocní mají značné až kolikovité bolesti břicha. Horečka i průjem trvají několik dní. Vzácně mohou kampylobaktery proniknout i do krve a způsobit tak poškození vnitřních orgánů.
Jak se určí diagnóza?
Diagnózu lze potvrdit pouze kultivací baktérií ze stolice.
Jaká je léčba?
Při průjmovém průběhu nemoci je nutná úprava hydratace zvýšeným příjmem tekutin. U malých dětí, které pijí nedostatečně, je třeba tekutiny dodávat v nemocnici v infúzích. Při těžkém průběhu s vysokými horečkami musí léčba probíhat v nemocnici a je nutné jim podávat antibiotika.